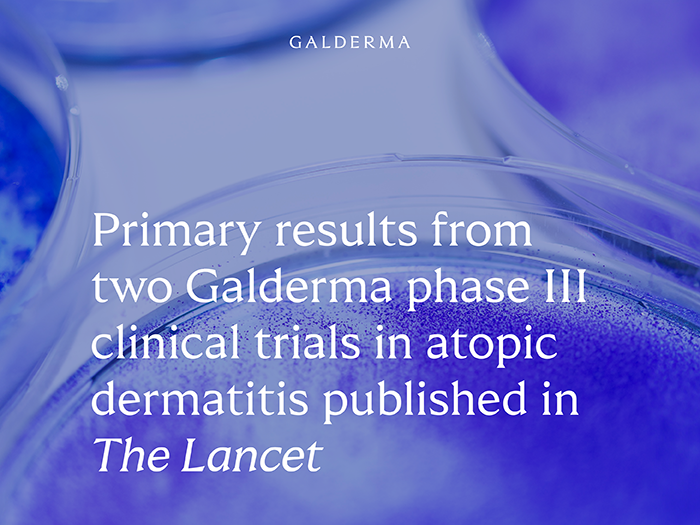

Phase III Arcadia 1 and 2 trial primary results published in The Lancet: Galderma’s nemolizumab improves key aspects of atopic dermatitis – itch, skin lesions and sleep disturbance
- Detailed results from the phase III ARCADIA 1 and 2 trials evaluating the safety and efficacy of nemolizumab in atopic dermatitis were published for the first time in The Lancet1
- Data from this phase III program demonstrate the potential of nemolizumab (in combination with background therapy) to improve key aspects of atopic dermatitis; skin lesions, itch, and sleep disturbance in adolescent and adult patients with moderate-to-severe atopic dermatitis1
- In the ARCADIA trials, statistically significant improvements in itch were observed as early as one week after nemolizumab treatment initiation1
- Nemolizumab is a first-in-class monoclonal antibody that inhibits the signaling of IL-31, a neuroimmune cytokine known to drive key signs and symptoms of atopic dermatitis2-5
Zug, Switzerland – July 25, 2024 – Galderma today announced that full results from the phase III ARCADIA 1 and 2 clinical trials in atopic dermatitis were published in The Lancet.1The trials evaluated the efficacy and safety of nemolizumab in combination with background topical corticosteroids (TCS), with or without topical calcineurin inhibitors (TCI), versus placebo in combination with TCS, with or without TCI, in adolescent and adult patients with moderate-to-severe atopic dermatitis.1 Results show that the trials met their co-primary and all key secondary endpoints, showing that nemolizumab significantly improved skin lesions, itch and sleep disturbance by Week 16 when compared to placebo, with significant itch relief observed as early as Week 1.1
“Publication of the phase III ARCADIA program results for the first time in The Lancet reinforces both the robustness of our trial design and the potential of nemolizumab as an effective treatment option for patients living with atopic dermatitis. We are working closely with regulators in the U.S., Europe, and elsewhere to bring nemolizumab to those in need as soon as possible.”
BALDO SCASSELLATI SFORZOLINI, M.D., Ph.D.
GLOBAL HEAD OF R&D
GALDERMA
The phase III ARCADIA 1 and 2 trials enrolled 1,728 adolescent and adult patients with moderate-to-severe atopic dermatitis.1 Results demonstrated that patients treated with nemolizumab, administered subcutaneously every four weeks in combination with TCS, with or without TCI, showed statistically significant improvements in both co-primary endpoints, when compared to placebo in combination with TCS, with or without TCI, after 16 weeks of treatment:1
- 36% and 38% of nemolizumab-treated patients in ARCADIA 1 and 2 achieved clear skin, defined by an investigator’s global assessment score of clear (0) or almost-clear (1), when compared to the placebo group (25% and 26%, respectively; p<0.001).
- 44% and 42% of nemolizumab-treated patients in ARCADIA 1 and 2 achieved at least a 75% improvement in the eczema area and severity index score, when compared to the placebo group (29% and 30%, respectively; p<0.001).
The trials also met all key secondary endpoints confirming rapid responses on itch, and statistically significant improvements in sleep disturbance with nemolizumab in combination with TCS, with or without TCI, when compared to placebo in combination with TCS, with or without TCI:1
- Clinically meaningful improvements in itch were observed as early as one week after nemolizumab treatment initiation when compared to placebo.
- An itch-free or nearly itch-free state (defined as a score of <2 on the peak pruritus numerical rating scale) was achieved by 16% of patients in both ARCADIA 1 and 2 at Week 4, after just one dose of nemolizumab, when compared to the placebo group (4% and 3%, respectively; p<0.001).
- At Week 16, 38% and 34% of nemolizumab-treated patients in ARCADIA 1 and 2 achieved at least a four-point improvement in the sleep disturbance numerical rating scale, when compared to the placebo group (20% and 16%, respectively; p<0.001).
The safety profile was consistent between nemolizumab and placebo groups; most treatment-emergent adverse events were non-serious, and of mild-to-moderate severity.1
“As a practicing dermatologist, I’m excited about the potential of nemolizumab for atopic dermatitis patients. These phase III data demonstrate that, by blocking the activity of IL-31, nemolizumab could effectively address itch, skin lesions and sleep disturbance. Many patients complain that chronic itch negatively impacts their overall quality of life. Reducing itch within just one week of treatment could significantly ease the burden of disease.”
Prof. Jonathan Silverberg
LEAD INVESTIGATOR OF THE ARCADIA CLINICAL PROGRAM,
Professor of Dermatology, George Washington University
School of Medicine and Health Sciences, United States
Based on the results of the ARCADIA 1 and 2 trials, the U.S. Food and Drug Administration accepted for review Galderma’s Biologics License Application for nemolizumab for the treatment of adolescents and adults with moderate-to-severe atopic dermatitis, with a decision expected by the end of the year.6 Galderma is awaiting decisions from several other regulatory authorities on its filing applications for both atopic dermatitis and prurigo nodularis, including the European Medicines Agency, Health Canada, and the Access Consortium.7 Regulatory submissions to other healthcare authorities around the world are ongoing.
Media can find more information about atopic dermatitis in this media toolkit page.
About atopic dermatitis
Atopic dermatitis a common, chronic, and flaring inflammatory skin disease, characterized by persistent itch and recurrent skin lesions.4,8,9 It affects more than 230 million people worldwide and is the most common inflammatory skin disease, impacting almost four times more people than psoriasis.4,10 While currently available treatments for atopic dermatitis show some improvements of signs and symptoms, not all patients experience itch relief and clear skin to the same degree, and many do not respond optimally to approved therapies.4,11
About nemolizumab
Nemolizumab is a monoclonal antibody developed by Galderma and is the first therapy designed to specifically inhibit interleukin-31 (IL-31) cytokine signaling.2 IL-31 signaling is known to drive the most burdensome symptom for people with atopic dermatitis and prurigo nodularis – itch.3-5
Nemolizumab is under review for both prurigo nodularis and atopic dermatitis by several regulatory authorities worldwide, including the U.S. Food and Drug Administration, European Medicines Agency and in Australia, Singapore, Switzerland, and the United Kingdom via the Access Consortium, with ongoing submissions in additional countries.6,7
Nemolizumab was initially developed by Chugai Pharmaceutical Co., Ltd., and subsequently licensed to Galderma in 2016 worldwide – except Japan and Taiwan. In Japan, nemolizumab is approved for the treatment of pruritus associated with atopic dermatitis and for prurigo nodularis.12,13
About the ARCADIA clinical trial program1,14,15
The ARCADIA program included two identically designed, pivotal phase III clinical trials, which enrolled more than 1,700 patients – ARCADIA 1 and ARCADIA 2.
These global, randomized, multicenter, double-blind, placebo-controlled phase III clinical trials, evaluated the efficacy and safety of nemolizumab administered subcutaneously every four weeks compared to placebo (both administered with background topical corticosteroids with or without topical calcineurin inhibitors).
The trials were conducted in adolescent and adult patients (12 years and over) with moderate-to-severe atopic dermatitis for an initial treatment phase of 16 weeks. Patients who responded to treatment (defined as patients who achieved an investigator’s global assessment score of clear (0) or almost clear (1), or a 75% or greater improvement in the eczema area and severity index score) were then re-randomized to a maintenance treatment phase for up to 48 weeks.
About Galderma
Galderma (SIX: GALD) is the emerging pure-play dermatology category leader, present in approximately 90 countries. We deliver an innovative, science-based portfolio of premium flagship brands and services that span the full spectrum of the fast-growing dermatology market through Injectable Aesthetics, Dermatological Skincare and Therapeutic Dermatology. Since our foundation in 1981, we have dedicated our focus and passion to the human body’s largest organ—the skin—meeting individual consumer and patient needs with superior outcomes in partnership with healthcare professionals. Because we understand that the skin we are in shapes our lives, we are advancing dermatology for every skin story. For more information: www.galderma.com
For further information:
|
Christian Marcoux, M.Sc. Chief Communications Officer christian.marcoux@galderma.com +41 76 315 26 50 |
Emil Ivanov Head of Strategy, Investor Relations, and ESG +41 21 642 78 12
|
|
Sébastien Cros Corporate Communications Director +41 79 529 59 85 |
Jessica Cohen Investor Relations and Strategy Director +41 21 642 76 43 |
References:
- Silverberg JI, et al. Nemolizumab with concomitant topical therapy in adolescents and adults with moderate-to-severe atopic dermatitis (ARCADIA 1 & 2): results from two replicate, double-blind, randomised controlled phase 3 trials. Lancet. 2024. doi: 10.1016/S0140-6736(24)01203-0
- Silverberg JI, et al. Phase 2B randomized study of nemolizumab in adults with moderate-to-severe atopic dermatitis and severe pruritus. J Allergy Clin Immunol. 2020;145(1):173-182. doi:10.1016/j.jaci.2019.08.013
- Bağci IS and Ruzicka T. IL-31: A new key player in dermatology and beyond. J Allergy Clin Immunol. 2018;141(3):P858-866. doi: 10.1016/j.jaci.2017.10.045
- Langan SM, Irvine AD, Weidinger S. Atopic dermatitis [published correction appears in Lancet. 2020;396(10253):758]. Lancet. 2020;396(10247):345-360. doi: 10.1016/S0140- 6736(20)31286-1
- Datsi A, et al. Interleukin-31: The “itchy” cytokine in inflammation and therapy. Allergy. 2021;76:2982-2997. doi: 10.1016/j.jaard.2020.04.183
- Galderma. Galderma announces regulatory filing acceptance for nemolizumab in prurigo nodularis and atopic dermatitis in the U.S. and EU. Available online. Last accessed July 2024
- Galderma. Galderma receives filing acceptance for nemolizumab in prurigo nodularis and atopic dermatitis in four additional countries. Available online. Last accessed July 2024
- Yang G, et al. Skin Barrier Abnormalities and Immune Dysfunction in Atopic Dermatitis. Int J Mol Sci. 2020;21(8): 2867. doi: https://doi.org/10.3390/ ijms21082867
- Ständer S. Atopic dermatitis. N Engl J Med. 2021;384(12):1136-1143. doi: 10.1056/NEJMra2023911
- Raharja A, et al. Psoriasis: a brief overview. Clin Med (Lond). 2021;21(3):170-173. doi: 10.7861/clinmed.2021-0257
- Lobefaro F, et al. Atopic dermatitis: Clinical aspects and unmet needs. Biomedicines. 2022;102927. doi: 10.3390/biomedicines10112927
- Chugai Pharmaceutical Co., Ltd. Maruho Obtained Regulatory Approval for Mitchga, the first Antibody Targeting IL-31 for Itching Associated with Atopic Dermatitis. Available online. Last accessed July 2024
- Chugai Pharmaceutical Co., Ltd. Mitchga Approved for Itching in Pediatric Atopic Dermatitis and Prurigo Nodularis, for its Subcutaneous Injection 30mg Vials. Available online. Last accessed July 2024
- ClinicalTrials.Gov. Efficacy & Safety of Nemolizumab in Subjects With Moderate- to-Severe Atopic Dermatitis (NCT03989349). Available online. Last accessed July 2024
- ClinicalTrials.Gov. Efficacy & Safety of Nemolizumab in Subjects With Moderate- to-Severe Atopic Dermatitis (NCT03985943). Available online. Last accessed July 2024